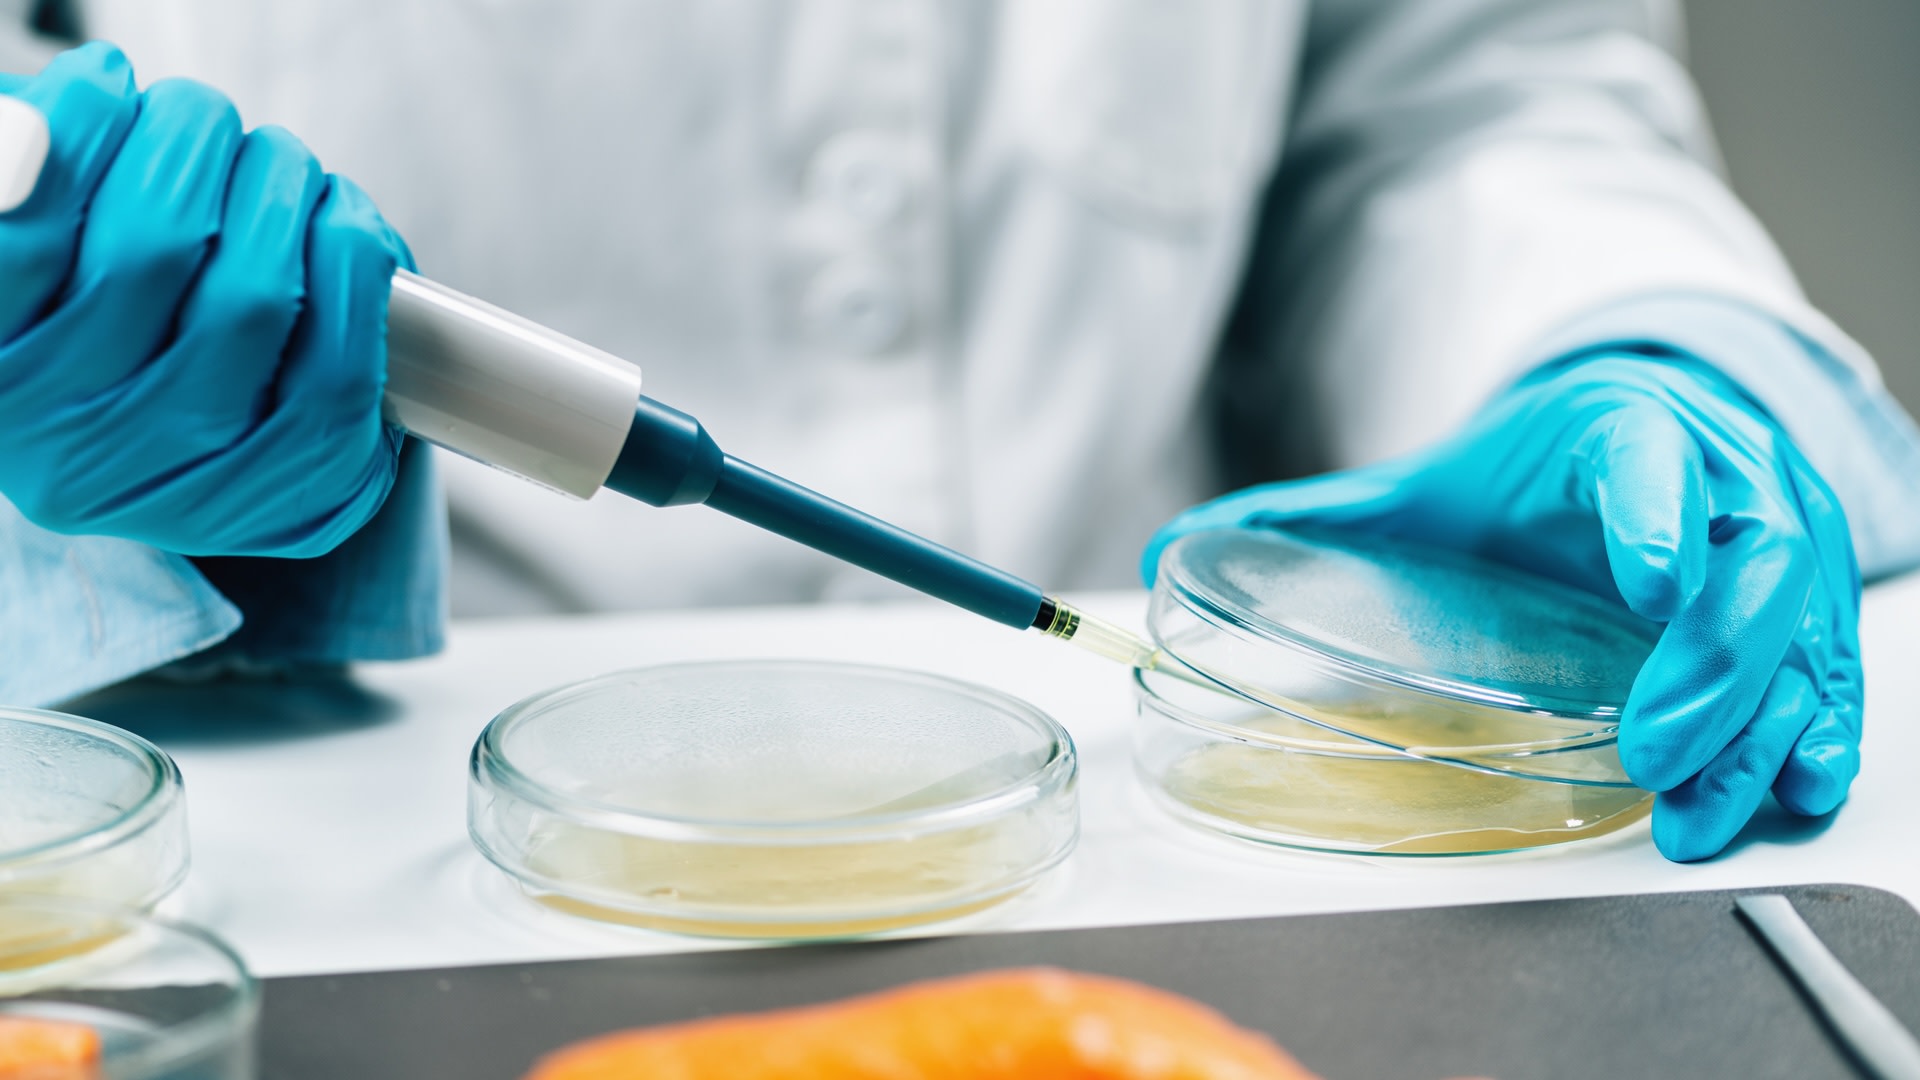

How much plastic are we really eating? Until now, it's been almost impossible to say for sure — but that may soon change thanks to a breakthrough method developed by researchers at Germany's Max Rubner-Institut.
The new procedure offers a standardized way to detect microplastics in seafood with more precision than ever before. That's a big deal because testing for the concentration of microplastics and nanoplastics varies widely, making it difficult to compare studies or assess health risks.
To tackle the problem, project lead Julia Süssmann and her team borrowed some ideas from environmental science and retooled them for food testing. One of the biggest challenges is breaking down organic material such as protein and fat without destroying the plastic particles themselves. The team overcame this by using a mix of enzymes, chemical digestion, and pressure filtration to isolate plastic particles from digested seafood tissue.
Next, the researchers used a fluorescent dye (Nile red) and semiautomated image analysis to distinguish plastic from natural particles such as shrimp shells. Their approach not only identifies the presence of plastic but also measures particle size and shape, which may help scientists understand how these contaminants behave in the human body.
The researchers also explored ways to detect nanoplastics — particles smaller than a micrometer — but found that current techniques fall short. Still, they confirmed microplastic contamination in seafood and other everyday foods. "Microplastic is not a problem restricted to seafood," said Süssmann. "In the course of our research we have found first evidence of plastic particles in milk, meat, eggs and honey."
Microplastic contamination is a growing concern for not only marine animals and other wildlife but also people. On top of that, plastic production is a major contributor to the heat-trapping emissions warming our planet and harming communities through air pollution and the associated more extreme weather events.
Get cost-effective air conditioning in less than an hour without expensive electrical work The Merino Mono is a heating and cooling system designed for the rooms traditional HVAC can't reach. The streamlined design eliminates clunky outdoor units, installs in under an hour, and plugs into a standard 120V outlet — no expensive electrical upgrades required. And while a traditional “mini-split” system can get pricey fast, the Merino Mono comes with a flat-rate price — with hardware and professional installation included. |
While the health risks are still being studied, scientists say understanding our exposure is an important first step. Such advances could lead to tighter food safety regulations and more consumer transparency while underscoring the need for us to reduce single-use plastics in the first place.
|
Do you worry about having toxic forever chemicals in your home?
Click your choice to see results and speak your mind. |
Join our free newsletter for weekly updates on the latest innovations improving our lives and shaping our future, and don't miss this cool list of easy ways to help yourself while helping the planet.